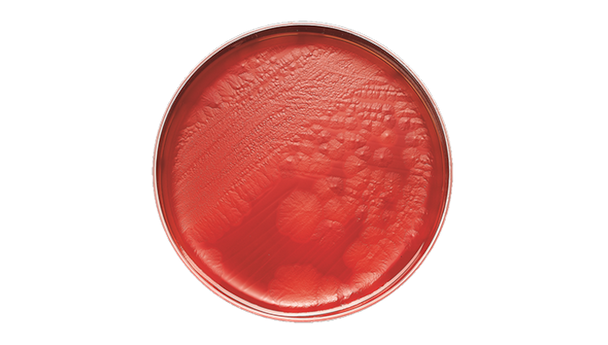
BD BBL CDC Anaerobe 5% Sheep Blood Agar Plate – 100 Plates, 70-Day Shelf Life, Prepared Culture Media

Description
BD BBL CDC Anaerobe 5% Sheep Blood Agar Plate is designed for laboratories that require reliable media for isolating and cultivating obligately anaerobic bacteria. When accuracy and consistency matter, this prepared culture media supports dependable results. Ideal for clinical labs and research settings that need a trusted solution for anaerobic bacterial growth.
- Formulated for Anaerobic Bacteria – Supports the isolation and cultivation of obligately anaerobic organisms, giving you confidence in your results.
- Developed by CDC Standards – Based on Centers for Disease Control and Prevention guidelines, ensuring high-quality performance for your lab.
- Ready-to-Use Plates – Arrive pre-prepared, saving time and reducing setup steps for busy laboratory teams.
- Consistent Shelf Life – 70-day shelf life helps with inventory planning and reduces waste.
Prepared Culture Media for Reliable Anaerobic Growth
This prepared culture media is engineered for the isolation and cultivation of obligately anaerobic bacteria, making it a dependable choice for clinical and research laboratories. Developed in line with CDC recommendations, these plates provide consistent colony morphology and growth for a wide range of anaerobic organisms. The 100-plate pack format supports high-throughput workflows and helps labs maintain efficiency. With a 70-day shelf life, this solution is ideal for facilities that need reliable media on hand for routine testing. Designed for microbiology professionals who value accuracy and convenience, this product helps streamline daily lab operations and supports confident results.
Features and Benefits
Optimized for Anaerobic Cultivation
- CDC-Based Formulation – Developed according to Centers for Disease Control and Prevention standards for consistent performance.
- Supports Colony Morphology – Enables clear observation of anaerobic bacterial colonies for accurate identification.
Convenience and Efficiency
- Pre-Prepared Plates – Ready to use out of the box, reducing preparation time for lab staff.
- Bulk Packaging – 100 plates per pack for efficient inventory management in busy labs.
Reliable Storage
- 70-Day Shelf Life – Provides predictable storage and reduces the risk of expired media.
Product Specifications
General Information
- Category: Prepared culture media
- Pack Size: 100 plates/pack
- Shelf Life: 70 days
Identification Codes
- SKU: 221734
- GTIN (Each): 00382902217343
- GTIN (Bag): 10382902217340
- GTIN (Shelfpack): 30382902217344
- GTIN (US Standard Pallet): 60382902217345
Explore More: See all Prepared Culture Media | Shop more BD BBL Products
Consistent Results and Trusted Performance
Choose this prepared culture media for its proven reliability and ease of use in anaerobic bacterial cultivation. The CDC-based formulation and bulk packaging help your lab maintain high standards and efficient workflows. You can count on steady performance and predictable results, making it a smart choice for laboratories focused on quality and consistency.
- CDC-Recommended Formula – Aligns with trusted guidelines for anaerobic culture, supporting laboratory confidence.
- Bulk Pack Advantage – 100 plates per pack means fewer restocks and smoother operations.
- Consistent Shelf Life – 70-day shelf life helps reduce waste and supports planning.
- Trusted Brand – Manufactured by BD BBL, a recognized leader in laboratory media solutions.
Frequently Asked Questions (FAQs)
What is the primary use of this prepared culture media?
This product is used for isolating and cultivating obligately anaerobic bacteria in laboratory settings.
How many plates are included in each pack?
Each pack contains 100 prepared agar plates for efficient laboratory workflows.
What is the shelf life of the plates?
The shelf life is 70 days, supporting predictable storage and inventory management.
Is this product based on CDC guidelines?
Yes, the formulation follows Centers for Disease Control and Prevention recommendations for anaerobic bacterial culture.
Who is the intended user for this product?
This prepared culture media is intended for use by clinical and research laboratory professionals.
Does the product require any preparation before use?
No, the plates are pre-prepared and ready to use upon arrival.
What is the packaging format?
The product comes in a bulk pack of 100 plates, ideal for high-volume laboratory use.